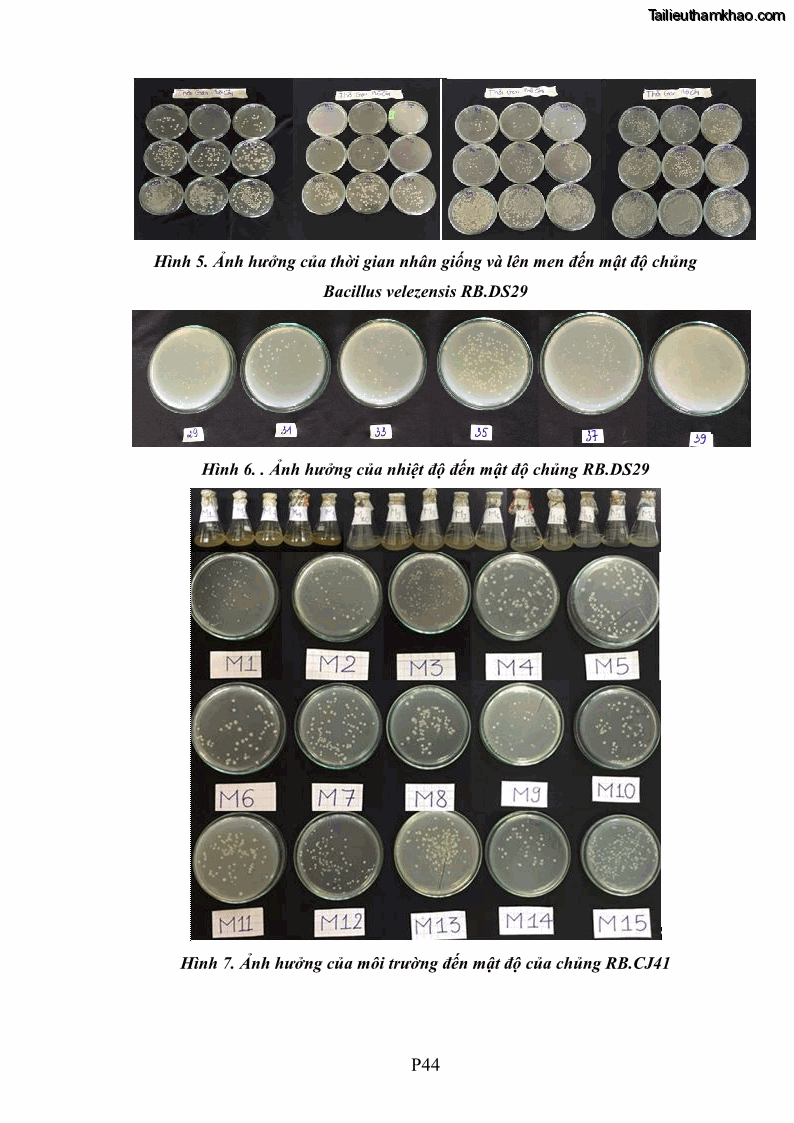
Trang 212
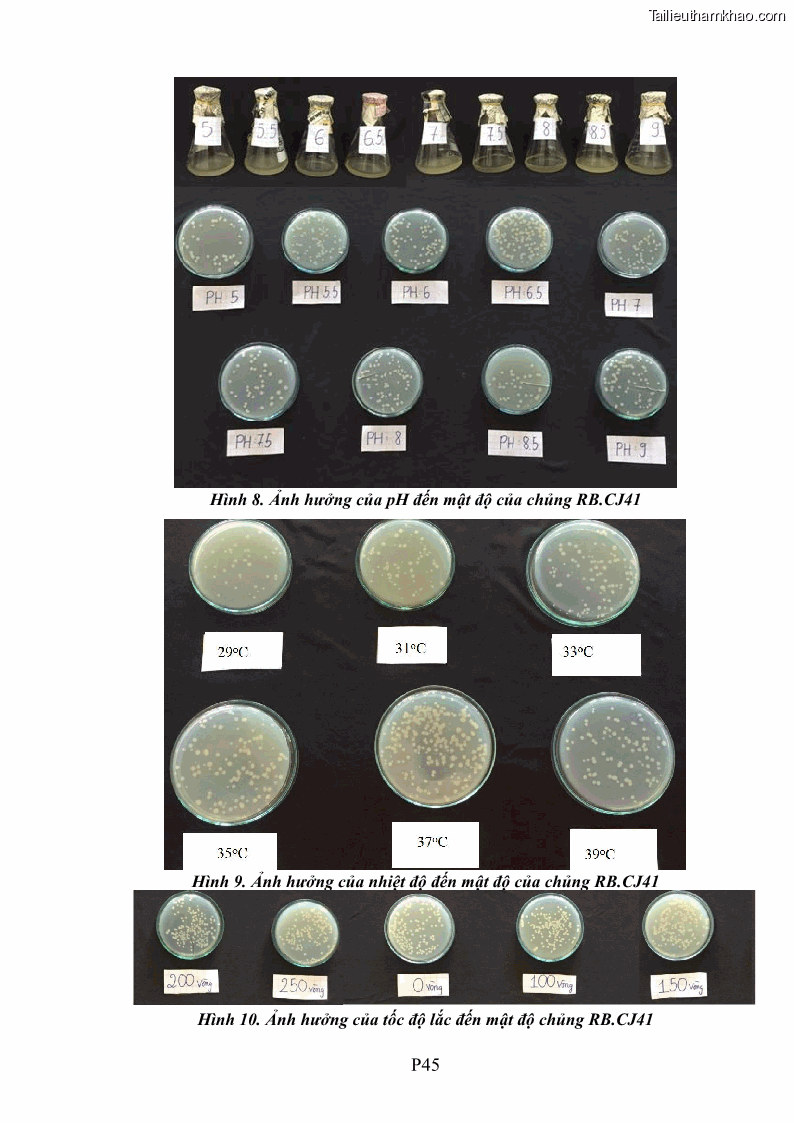
Trang 213
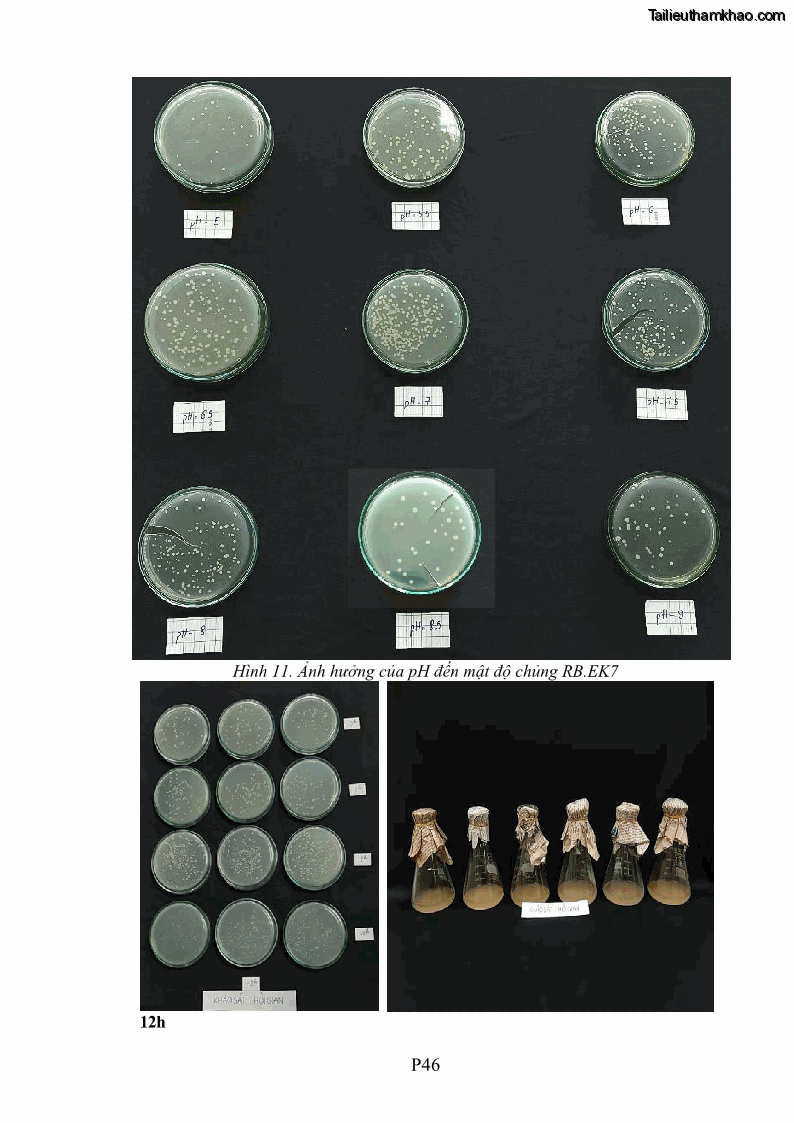
Trang 214

Luận án tiến sĩ công nghệ sinh học Tuyển chọn, nghiên cứu đặc tính kháng tác nhân gây bệnh và tạo chế phẩm phòng trừ bệnh rễ của các chủng vi khuẩn vùng rễ cây hồ tiêu Piper nigrum L. tại Tây Nguyên - 27 Trang 209
Có thể bạn quan tâm!
-
Luận án tiến sĩ công nghệ sinh học Tuyển chọn, nghiên cứu đặc tính kháng tác nhân gây bệnh và tạo chế phẩm phòng trừ bệnh rễ của các chủng vi khuẩn vùng rễ cây hồ tiêu Piper nigrum L. tại Tây Nguyên - 24 -
Luận án tiến sĩ công nghệ sinh học Tuyển chọn, nghiên cứu đặc tính kháng tác nhân gây bệnh và tạo chế phẩm phòng trừ bệnh rễ của các chủng vi khuẩn vùng rễ cây hồ tiêu Piper nigrum L. tại Tây Nguyên - 25 -
Luận án tiến sĩ công nghệ sinh học Tuyển chọn, nghiên cứu đặc tính kháng tác nhân gây bệnh và tạo chế phẩm phòng trừ bệnh rễ của các chủng vi khuẩn vùng rễ cây hồ tiêu Piper nigrum L. tại Tây Nguyên - 26 -
Luận án tiến sĩ công nghệ sinh học Tuyển chọn, nghiên cứu đặc tính kháng tác nhân gây bệnh và tạo chế phẩm phòng trừ bệnh rễ của các chủng vi khuẩn vùng rễ cây hồ tiêu Piper nigrum L. tại Tây Nguyên - 28

Trang 210

Trang 211
Trang 212
Trang 213
Trang 214

Trang 215

Trang 216




